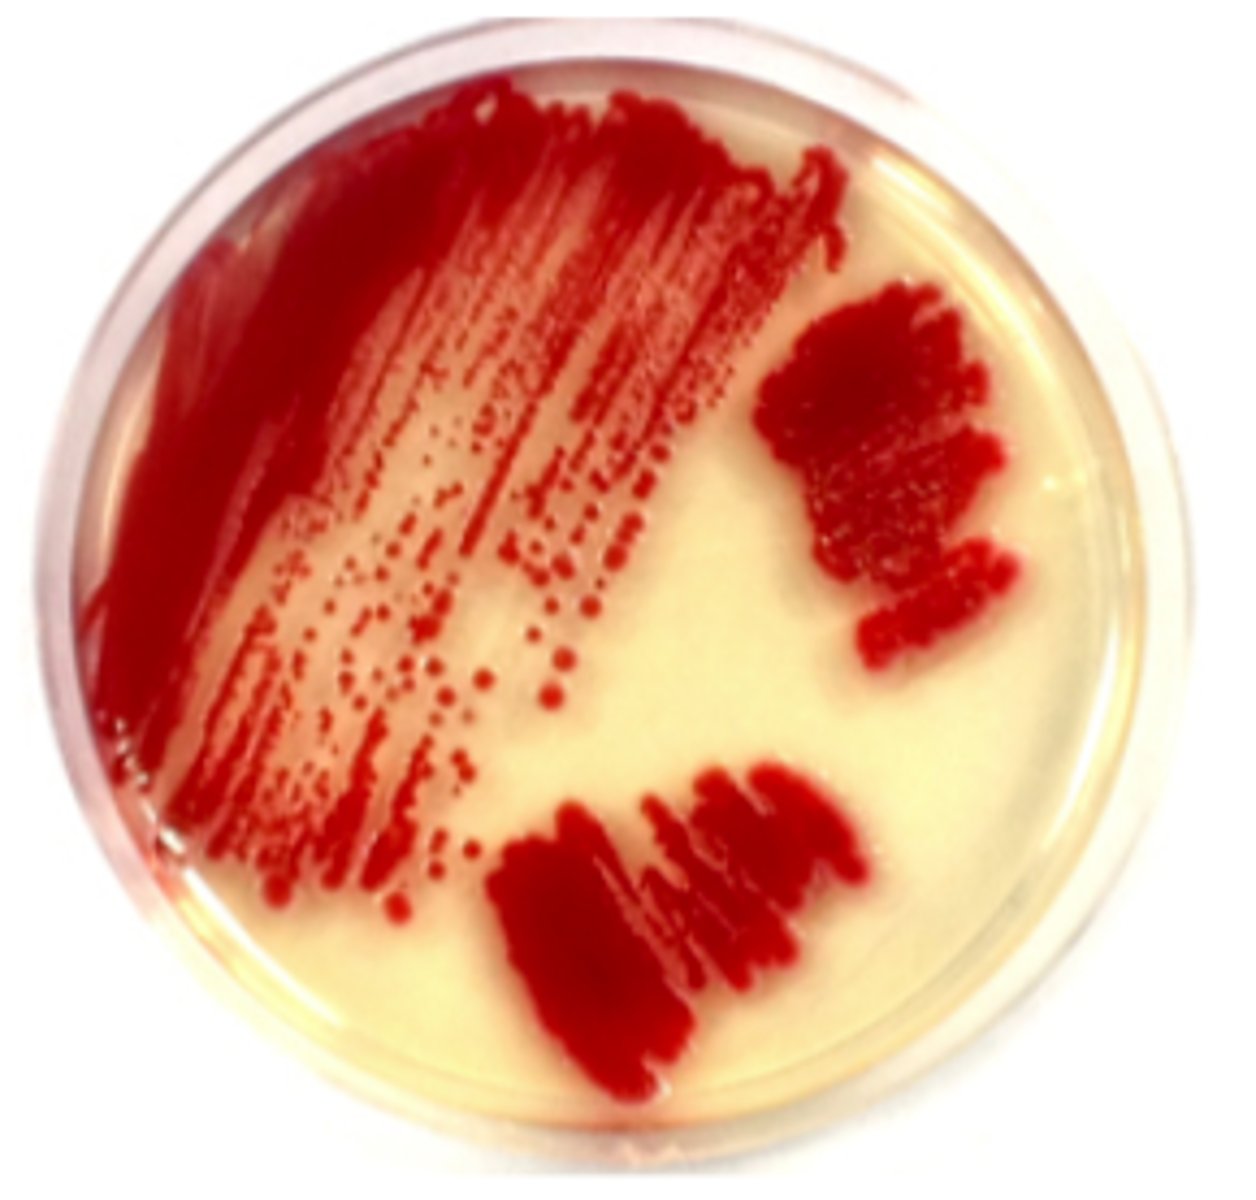
<p>one supplemented with a highly nutritious materials,</p><p>to allow growth of very fastidious microorganisms</p>
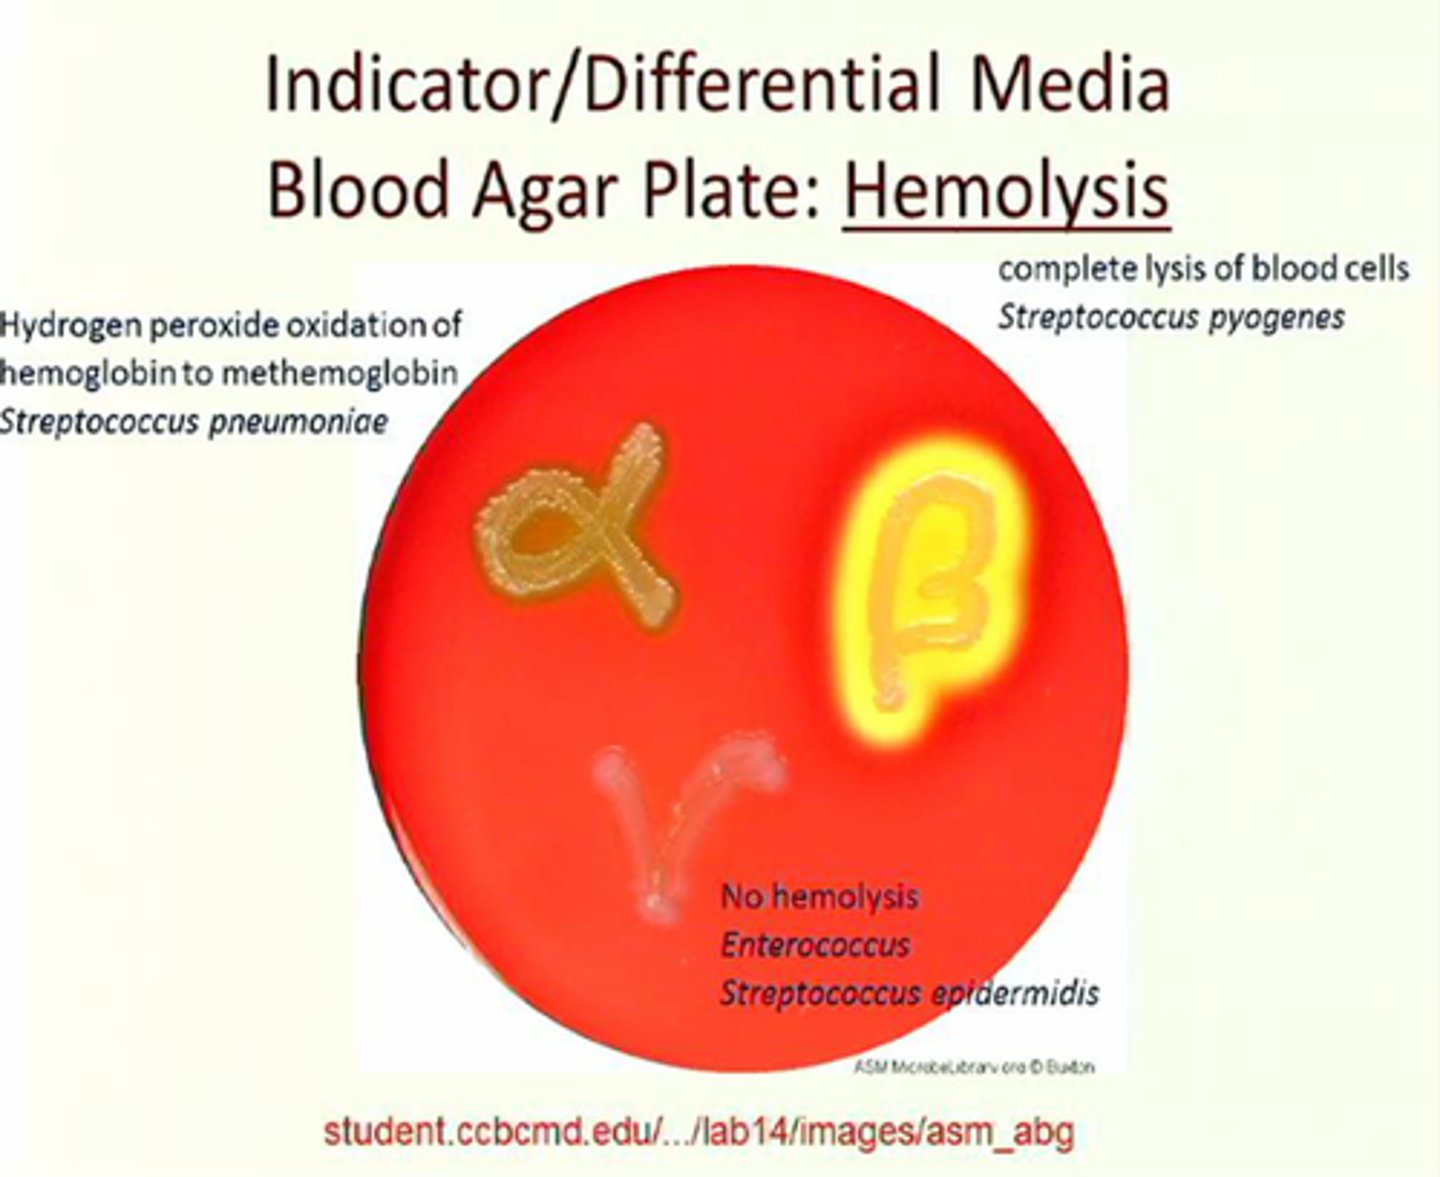
<p>gamma hemolysis</p><p>alpha hemolysis</p><p>beta hemolysis</p>
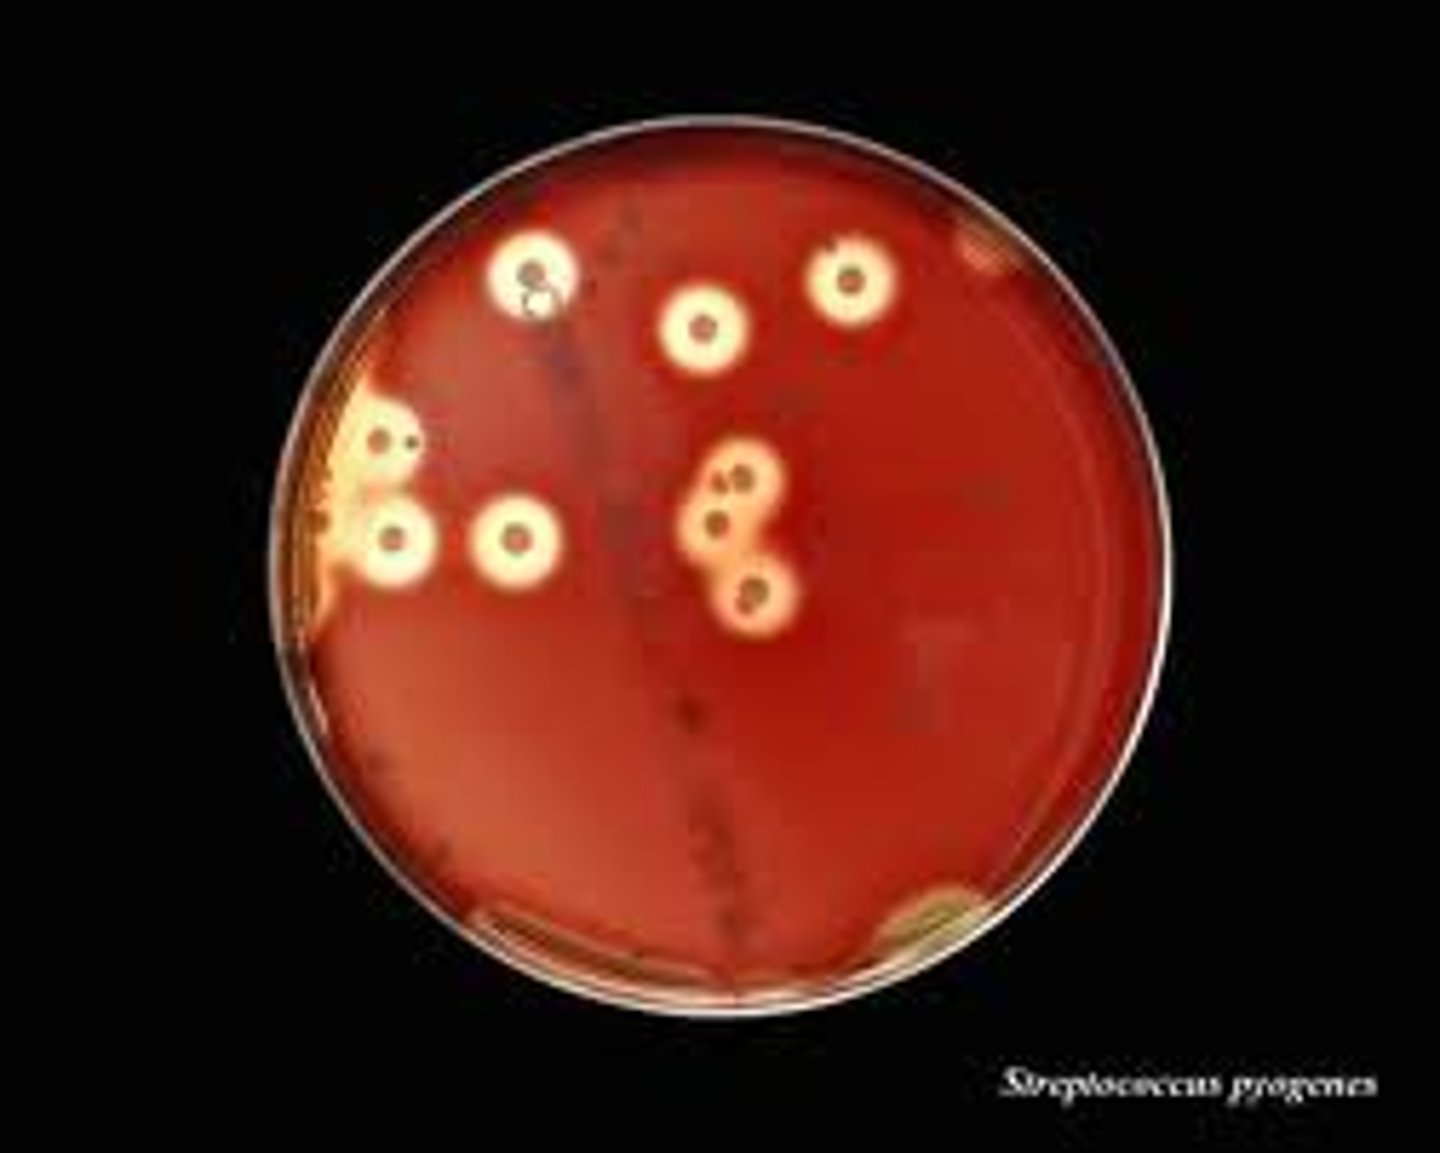
<p>The zone around colony growth is a clear halo; complete hemolysis; Staphylococcus areus or Streptococcus pyogenes</p>
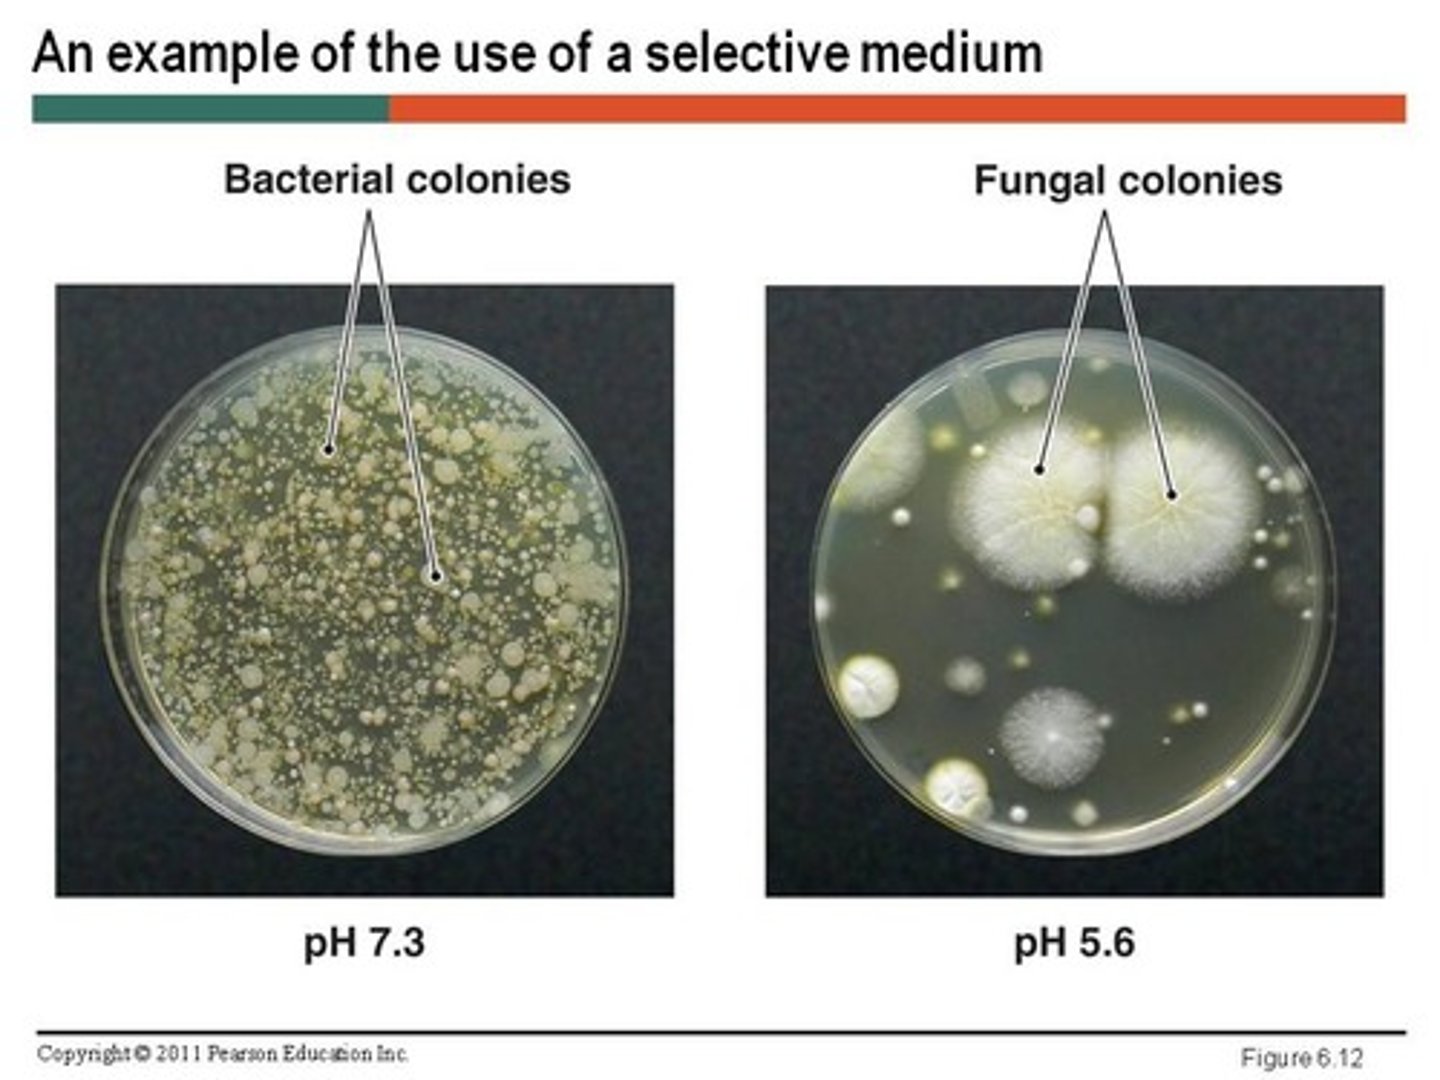
<p>one to which compound have been added to selectively inhibit the growth of certain microorganism but not others. they incorporate chemical that inhibit growth of certain bacteria while permitting growth of another. thus isolates or selects one particular group.</p>
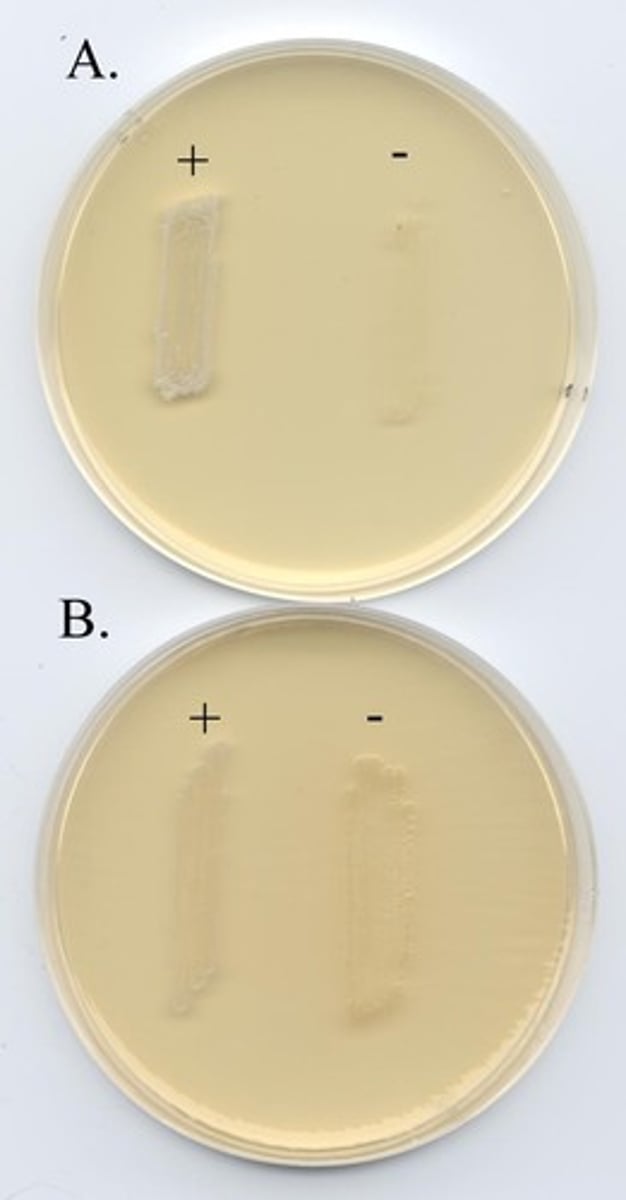
<p>used for isolation/selection of most gram positive bacteria; inhibits most gram negative bacteria</p>
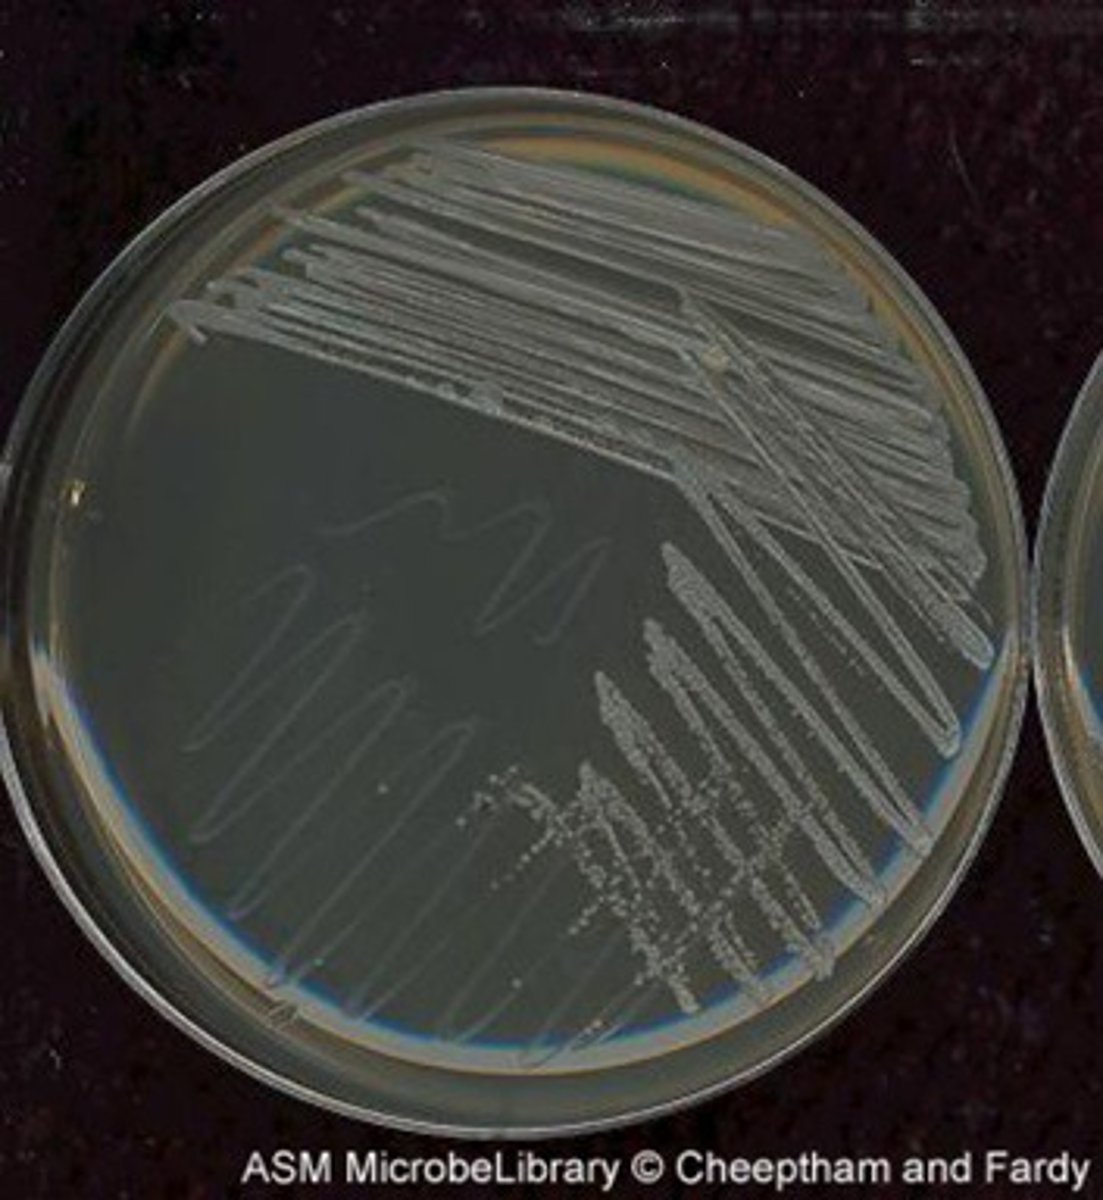
knowt flashcard image
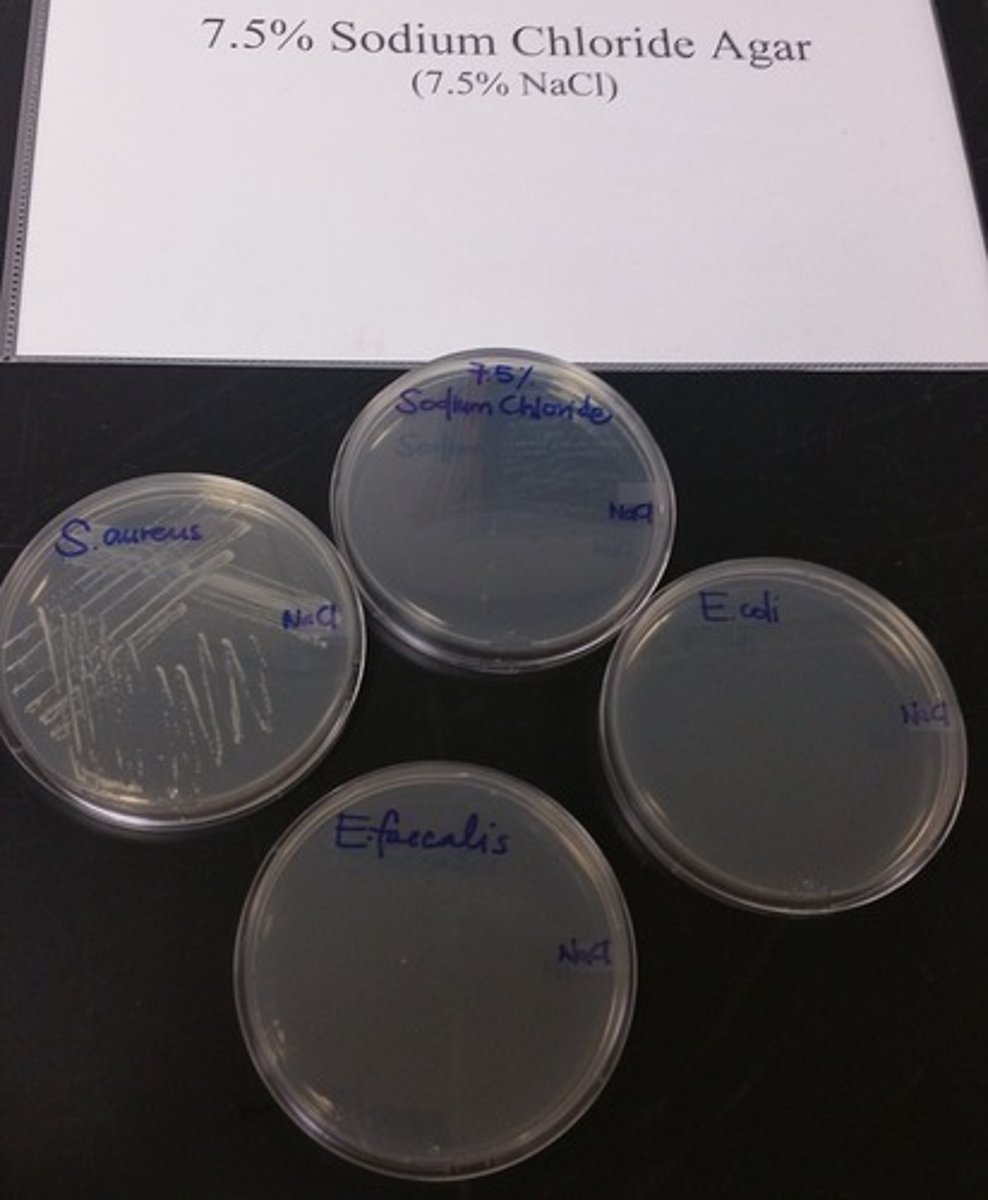
<p>This medium is inhibitory to most organism other than halophilic (salt-loving) microorganism. most useful for the detection of staphylococcus.</p>
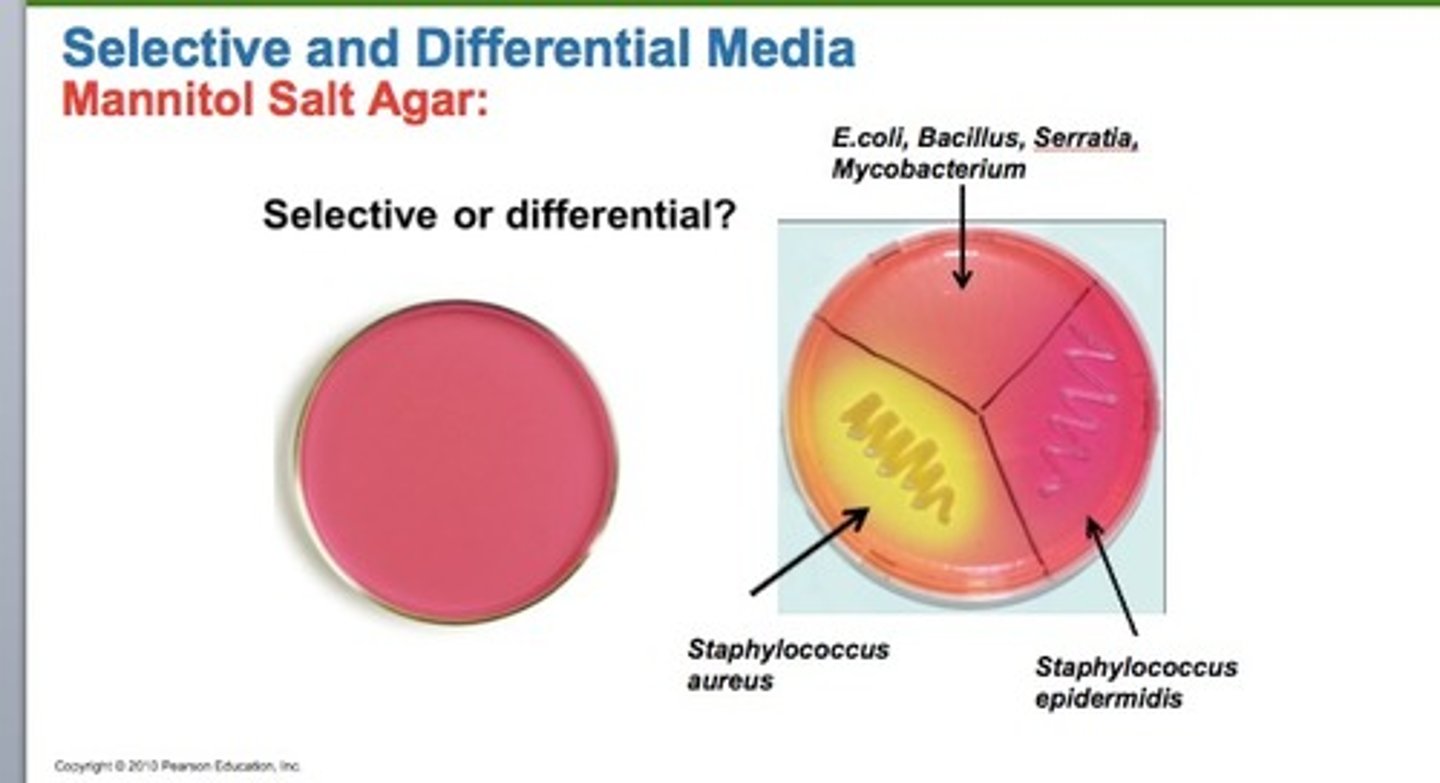
<p>one to which some sort of an indicator, usually a dye or ph indicator, has been added, which allows you to differentiate between various chemical reactions carried out during growth.</p>
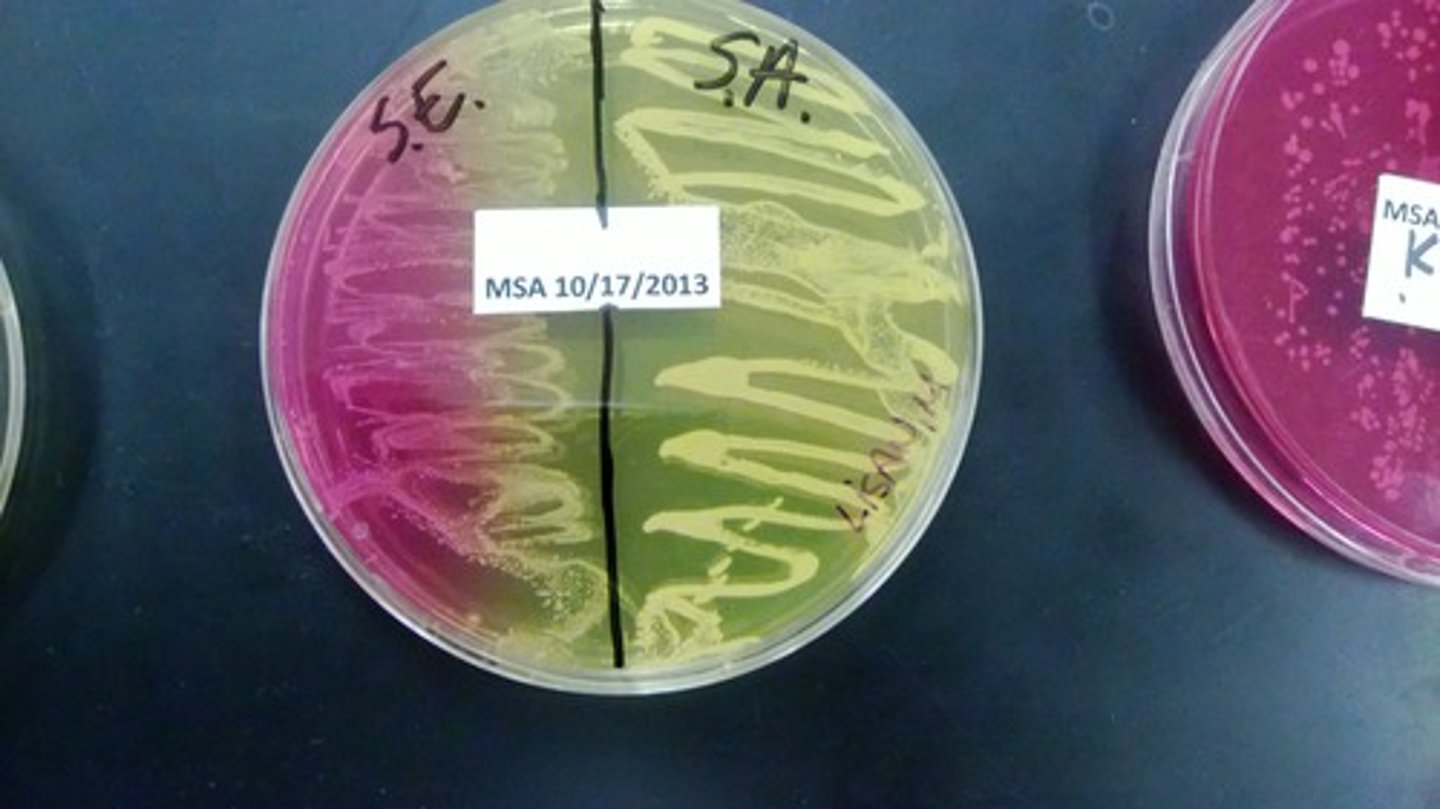
<p>mannitol- some organism ferment producing acid</p><p>phenol red- pH indicator (yellow at Ph 6.8; red at pH 7)</p>
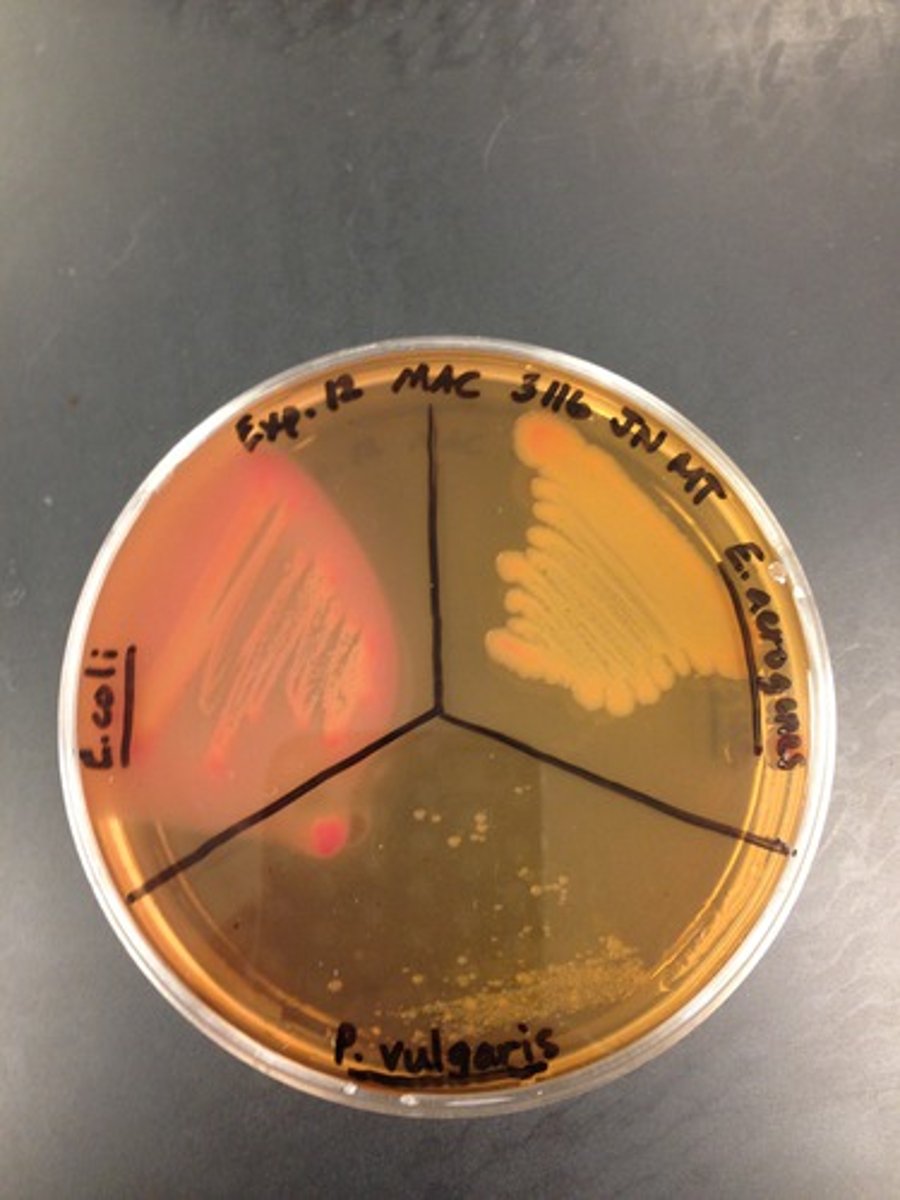
<p>medium contains bile salts and crystal violet which inhibits gram positive (Staphylococcus), thereby isolating gram negative enteric</p>
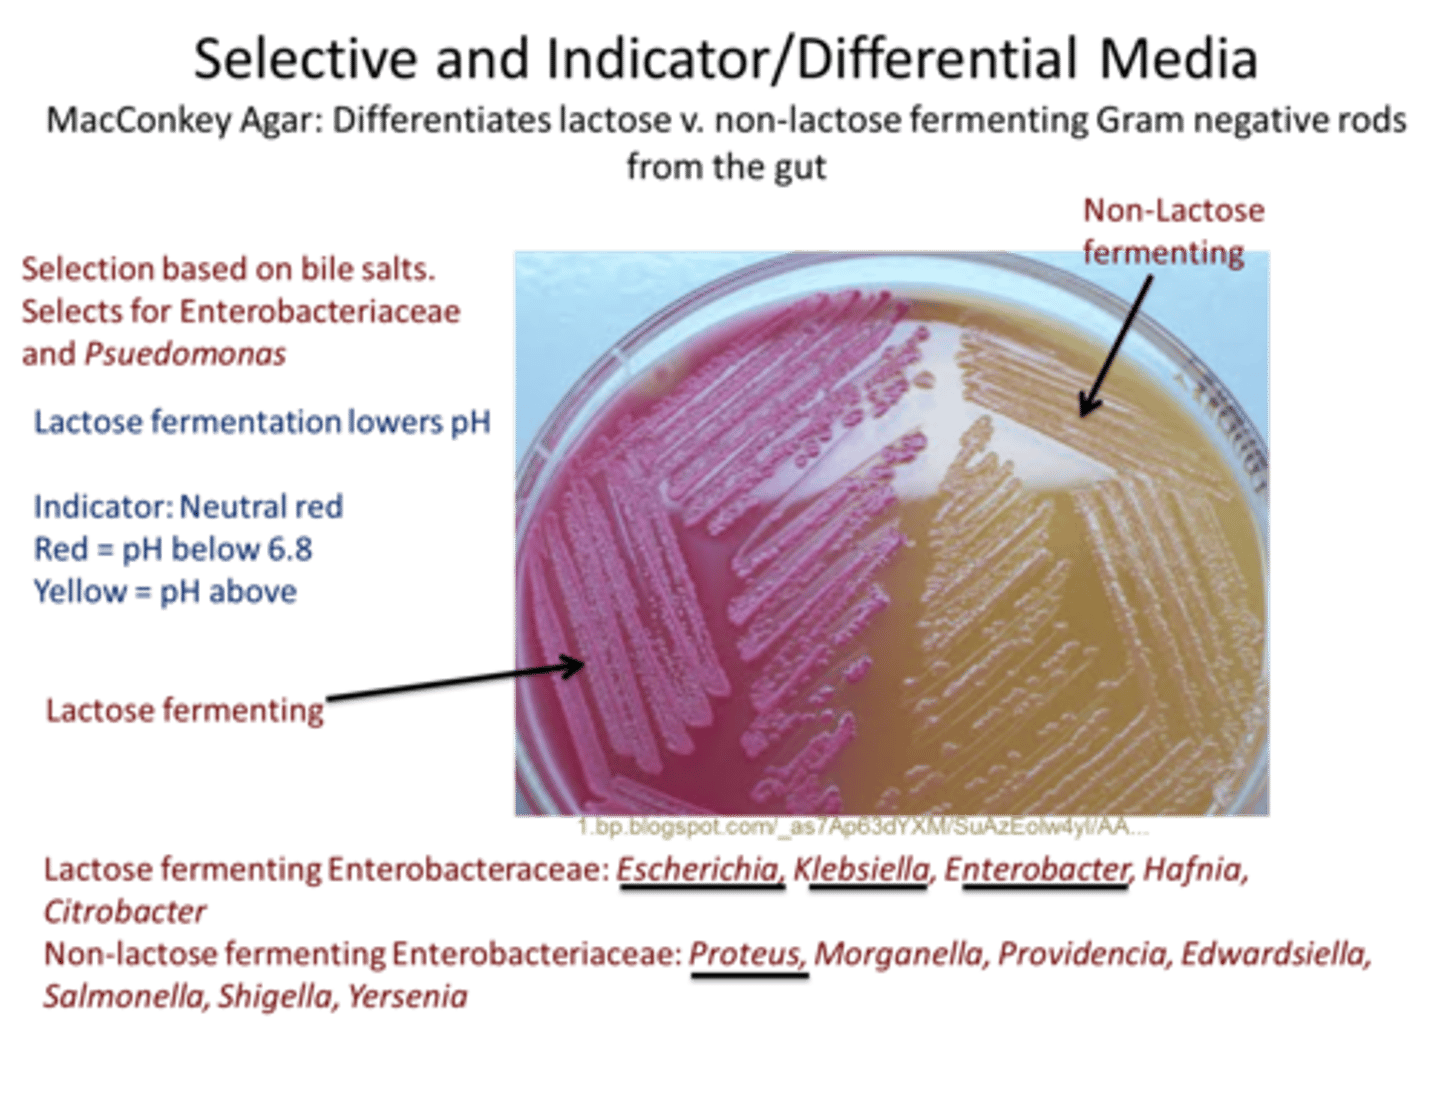
<p>*Coliform Bacteria (Escherichia coli and/or Enterobacter aerogenes)</p><p>- Growth (Gram negative, enteric)</p><p>- Pink-red color on colony surface because is a lactose fermenter</p><p>** Typhoid, Paratyphoid and Dysentery bacteria (Salmonella)</p><p>-Growth (Gram negative, enteric)</p><p>-White/transparent streak on colony surface because is not a lactose fermenter (nonfermenter</p>
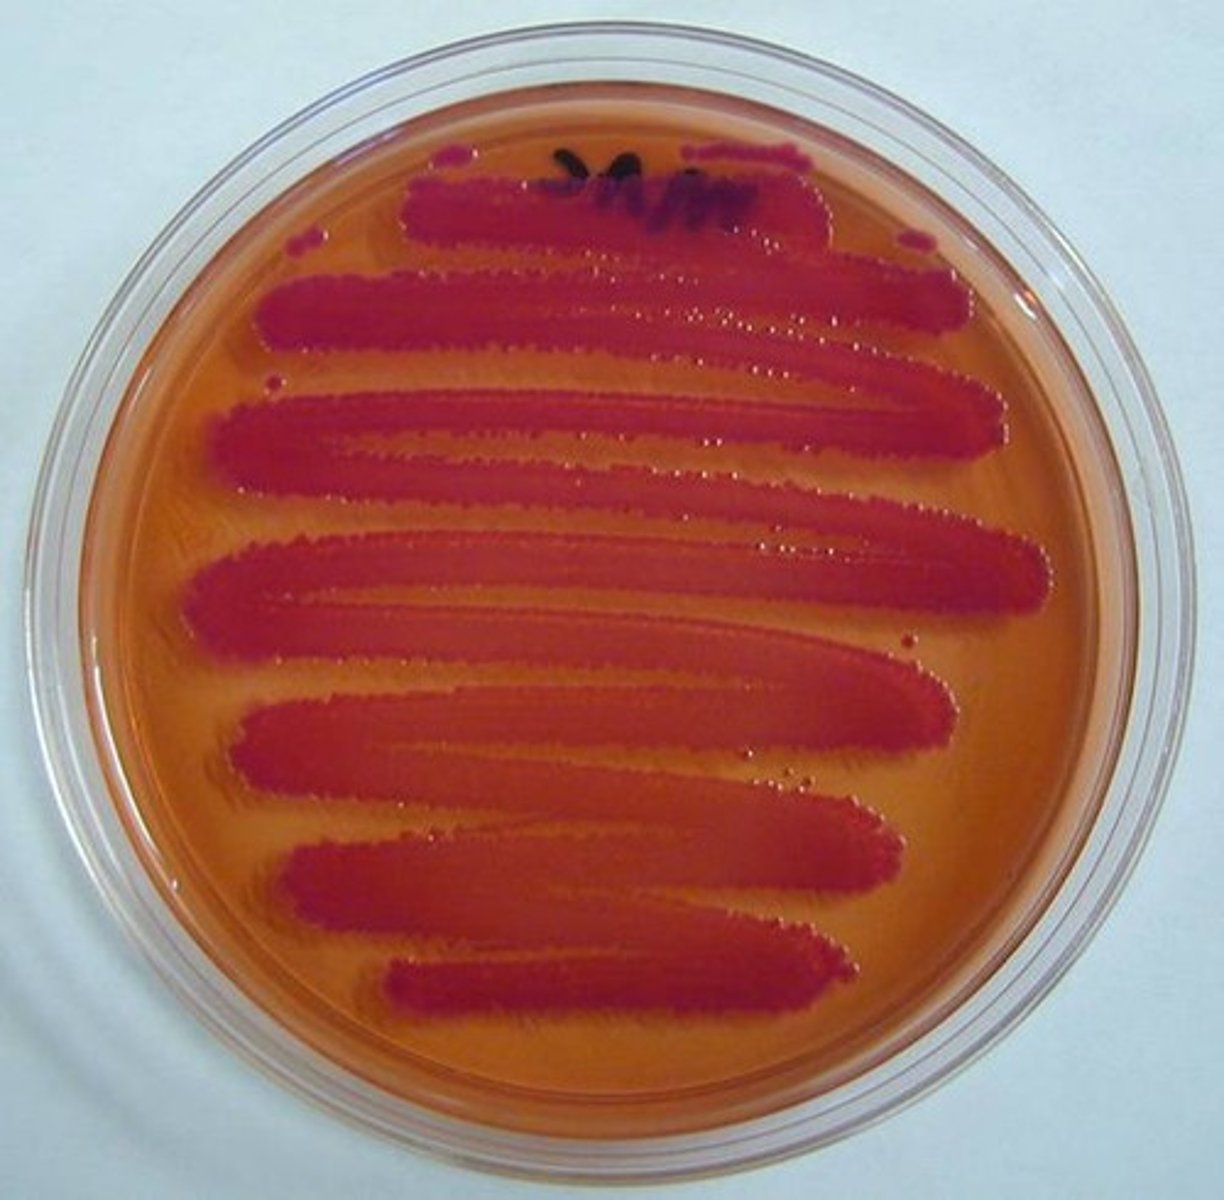
<p>They are E.coli and Enterobacter aerogenes. Grow on MAC, produce acid as a result of lactose fermentation. exhibit red coloration on their surface.</p><p>example-E.coli produce greater quantities of acid from lactose than other coliform species.</p><p>when this happens medium surrounding becomes hot pink.</p>
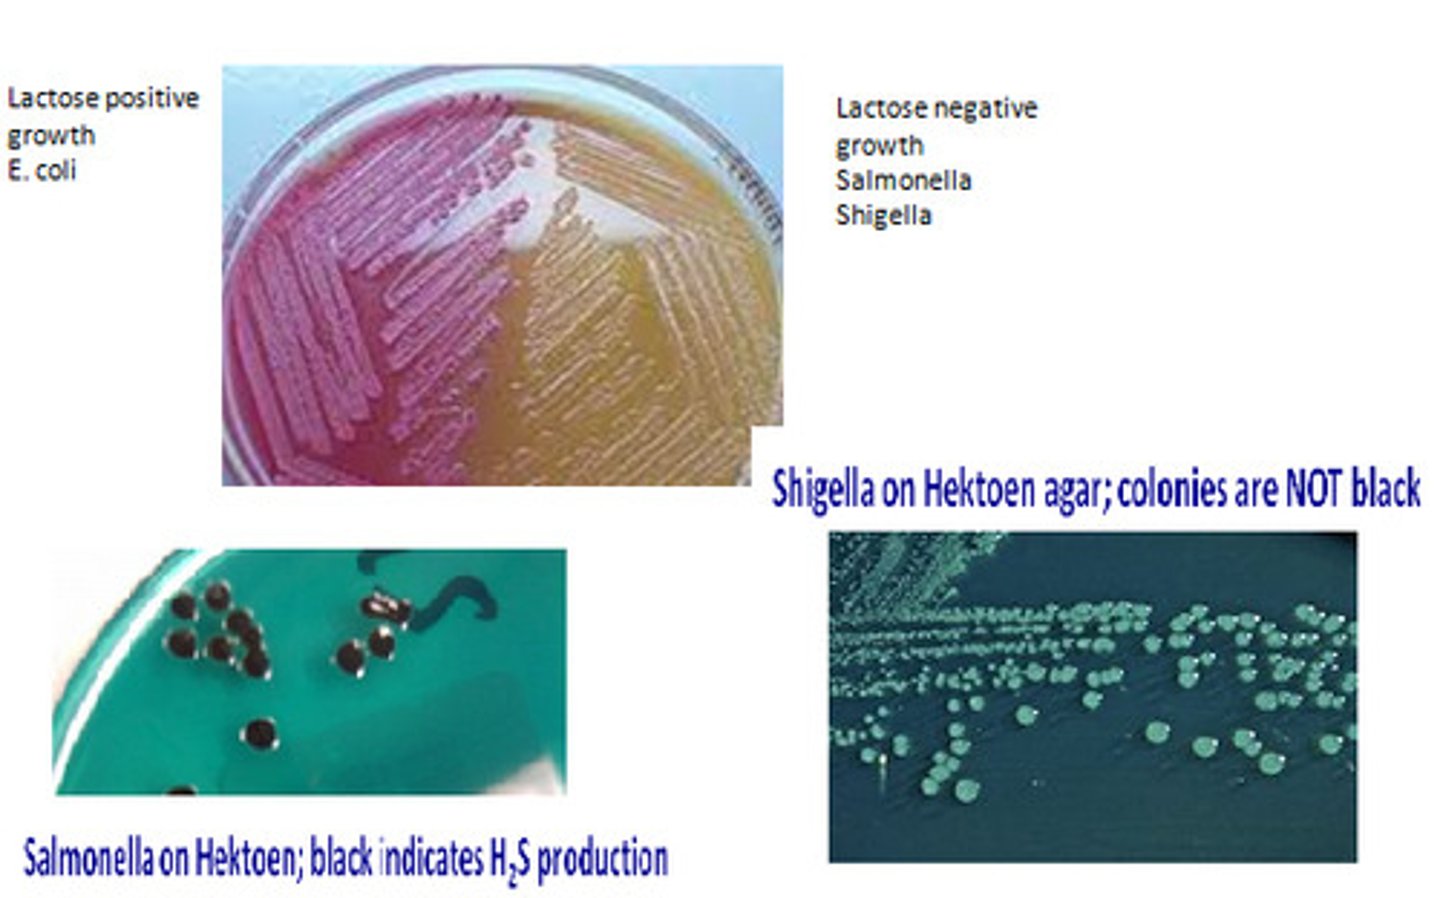
<p>enteric bacteria; found in intestinal tract of mammals; short in size, gram neg, non-spore forming, bacilli (i.e pathogens- salmonella and shigella, occasional pathogens- proteus and klebsiells, and normal intestinal flora- escherichia and enterobacter)</p>

Micro lab final, 2016
1/132
There's no tags or description
Looks like no tags are added yet.
Name | Mastery | Learn | Test | Matching | Spaced | Call with Kai |
|---|
No analytics yet
Send a link to your students to track their progress
133 Terms
subculturing process
process of transferring bacteria from one plate to another
purpose of subculturing
allows easier study and organization of bacterial isolates
gram-positive bacteria
poor growth or no growth, organism is inhibited by crystal violet and/or bile

gram-negative bacteria
Good growth, organism is not inhibited by crystal violet or bile

use of media
Media are used for: 1. isolation 2. differentiation 3. enumeration
4. analysis 5. characterization & identification
enriched media
one supplemented with a highly nutritious materials,
to allow growth of very fastidious microorganisms
example of enriched
blood agar- for cultivation of fastidious organism such as streptococcus spp.
TSA agar enriched with 5% sheep blood shows hemolysis of RBC's by certain organisms
purpose of enriched media
It is used when the growth of specific organisms is desired. The media is supplemented with the nutrients that the organism needs.
classification of hemolytic activity
gamma hemolysis
alpha hemolysis
beta hemolysis
Alpha (α) hemolysis
The zone around colony growth is a greenish halo; partial hemolysis; Streptococcus sanguinis

Beta (β) hemolysis
The zone around colony growth is a clear halo; complete hemolysis; Staphylococcus areus or Streptococcus pyogenes
Gamma (γ) hemolysis
(no hemolysis); no zone around colony growth;
Staphylococcus epidermidis

selective media
one to which compound have been added to selectively inhibit the growth of certain microorganism but not others. they incorporate chemical that inhibit growth of certain bacteria while permitting growth of another. thus isolates or selects one particular group.
Examples of selective
1.phenylethyl alcohol agar (PEA)
2. crystal violet agar
3. 7.5% sodium chloride (NaCl) agar
purpose of selective media
It's used for the growth of specific bacteria, which is based on the composition of media.
phenylethyl alcohol agar (PEA)
used for isolation/selection of most gram positive bacteria; inhibits most gram negative bacteria
Result of PEA
crystal violet agar
This medium is selective for gram negative bacteria; inhibits gram positive bacteria

purpose of crystal violet agar
Crystal violet (as well as bile salts) selects for Gram negative bacteria.
7.5% sodium chloride (NaCl) agar
This medium is inhibitory to most organism other than halophilic (salt-loving) microorganism. most useful for the detection of staphylococcus.
differential media
one to which some sort of an indicator, usually a dye or ph indicator, has been added, which allows you to differentiate between various chemical reactions carried out during growth.
Types of differential
1.mannitol salt agar
2.macConkey agar
3.Eosin-methylene blue agar (levine)
*note- all these have both differential and selective characteristics
purpose of differential media
used for differentiating closely related organisms or groups of organisms. Because of the presence of certain dyes or chemicals in the media, the organisms will produce certain characteristic changes or growth patterns that are used for identification or differentiation of microorganism.
Mannitol salt agar (MSA)- selective
medium contains high salt concentration (7.5% NaCl) which selects for the genus staphylococcus

Mannitol salt agar (MSA)-differential
mannitol- some organism ferment producing acid
phenol red- pH indicator (yellow at Ph 6.8; red at pH 7)
Purpose of MSA
Mannitol Salt agar is used to differentiate between staph fermentors and non-fermentors. It only allows growth of Staphyloccus. The plates turn yellow if the bacteria are able to ferment the mannitol
pathogenic staphylococcus
Staphylococcus aureus grows on MSA and ferment mannitol, producing an acid, which turns the phenol red in the medium to yellow

non-pathogenic staphylococcus
Staphylococcus epidermis, grow on MSA, but don't ferment mannitol, so no color changes to medium around growth ( medium always red)
MacConkey agar
good example of combination (selective and differential) because it contains bile salts and crystal violet, which inhibit gram-positive bacteria and allow gram-negative to grow

MacConkey's agar (MAC)-selective
medium contains bile salts and crystal violet which inhibits gram positive (Staphylococcus), thereby isolating gram negative enteric
MacConkey's agar (MAC)- differential
*Coliform Bacteria (Escherichia coli and/or Enterobacter aerogenes)
- Growth (Gram negative, enteric)
- Pink-red color on colony surface because is a lactose fermenter
** Typhoid, Paratyphoid and Dysentery bacteria (Salmonella)
-Growth (Gram negative, enteric)
-White/transparent streak on colony surface because is not a lactose fermenter (nonfermenter
Is MacConkey Agar gram+ or gram-?
gram-
Purpose of MAC
used to isolate and differentiate members of the Enterobacteriaceae based on the ability to ferment lactose
What is the media of MacConkey Agar?
1 Lactose 2 Bile salts 3 Crystal violet 4 Neutral red
What is the purpose of Lactose in MacConkey agar?
Used as a source fermentation for some gram negative bacteria, produces acid. If fermented turns the dye red(pink)
What is the purpose of Bile Salts & Crystal Violet?
inhibits the growth of gram+ bacteria. Bile produce red color
What is the purpose of Neutral red?
act as a pH indicator, colorless at high Ph and red at low Ph
coliform bacilli
They are E.coli and Enterobacter aerogenes. Grow on MAC, produce acid as a result of lactose fermentation. exhibit red coloration on their surface.
example-E.coli produce greater quantities of acid from lactose than other coliform species.
when this happens medium surrounding becomes hot pink.
dysentry, typhoid, and paratyphoid bacilli
They are Salmonella that grow on Mac because it's gram negative, enteric
White/transparent streak on colony surface because is not a lactose fermenter (nonfermenter)
Eosin-methylene blue agar (levine)-selective
Eosin Y and methylene blue partially inhibit growth of gram positive, therefore isolating gram negative enteric
"Poor Growth or No Growth" on MacConkey Agar means
Organism is inhibited by Crystal Violet and/or Bile Salts. It's Gram-Positive species,
"Good Growth" on McConkey Agar means
Organism is not inhibited by Crystal Violet and Bile Salts. It's Gram-Negative species
"Pink to Red Growth without Bile Precipitate" on McConkey Agar means
Organism produces Acid from Lactose Fermentation. Probable Coliform bacteria (E.coli)
"Growth is Colorless (not Red or Pink)" on McConkey Agar means
Organism does not ferment lactose: No Reaction. typhoid, paratyphoid or dysentry bacteria i.e. Salmonella
What type of Agar is Eosin Methylene Blue (EMB) ?
Is a complex, selective, and differential medium.
main constituents of Eosin Methylene Blue agar are
-Peptone
-Lactose
-Sucrose
-Eosin Y (Dye)
-Methylene Blue (Dye)
purpose Sucrose and lactose in Eosin Methylene Blue (EMB) Agar?
Sucrose supports pathogens such as Proteus or Salmonella species, lactose supports coliforms such as Escherichia coli. Sucrose and lactose serve as fermentable carbohydrate sources which encourage the growth of fecal coliforms and provide a means of differentiating them.
What is the purpose of the Dyes in Eosin Methylene Blue (EMB) Agar?
Eosin Y and methylene blue are pH indicator dyes which combine to form a dark purple precipitate at low pH; they also serve to inhibit the growth of most Gram positive organisms.
Eosin-methylene blue agar (levine)- differential
lactose or sucrose, some enteric bacteria ferment, producing acid and accumulation, then causes colonies to change color
Vigorous fermenters
They are E.coli that grow on EMB, ferment lactose or sucrose, producing lot of acid quickly.
Bacteria colonies appear blue black w/ metallic green sheen

What is Eosin Methylene Blue (EMB) Agar used for?
Used for the isolation of Fecal Coliforms.
What organisms were used in the Eosin Methylene Blue (EMB) Agar experiment?
1. Enterobacter aerogenes (slow fermenter)
2. Staphylococcus epidermus (no fermenter)
3. Escherichia coli (vigorous fermenter)
"Poor growth or no growth" in Eosin Methylene Blue (EMB) Agar means
Organism is inhibited by Eosin Y and Methylene Blue. It's Gram Positive species
"Good Growth" in Eosin Methylene Blue (EMB) Agar means
Organism is not inhibited by the Eosin and Methylene Blue. It's Gram-Negative species
"Growth is pink and mucoid" in Eosin Methylene Blue (EMB) Agar means
Slower (lactose or sucrose) fermenter, producing acid slowly over time
It is Enterobacter aerogenes
"Growth is Dark (Purple to Black)" in Eosin Methylene Blue (EMB) Agar means
Indicates a Vigorous (lactose or sucrose) fermenter, producing a lot of acid quickly.
It's Escherichia coli, also has Green Metallic Sheen
"Growth is colorless (No Pink, Purple, or Metallic Sheen" in Eosin Methylene Blue (EMB) Agar means
Organism does NOT Ferment Lactose or Sucrose. It's Noncoliform (Enterobacter or Klebsiella or staphylococcus)
slower fermenters
Enterobacter aerogenes, grow on EMB, Color of growth is mucoid pink/purple indicating Slower (lactose or sucrose)
fermenter, producing acid slowly over time
non-fermenters
grow on EMB, produce no acid
appear colorless/transparent
example-salmonella shigella
aerobic respiration
oxygen serve as the final electron acceptor

anaerobic respiration
inorganic ions other than oxygen serve as the final electron acceptor

fermentation
oxygen is not required; an organic substrate serves as the final electron acceptor

carbohydrate fermentation
metabolic process in which carbohydrates are used to convert sugars to acids, gases, and/or alcohols for energy; this is an aerobic test; i.e embden-meyerhof pathway

Embden-Meyerhof Pathway (a.k.a. the Glycolic pathway
glucose--pyruvic acid--a variety of end products
catalase
is an enzyme that degrades hydrogen peroxide into WATER and OXYGEN
catalase test
Subculture microorganism(s) onto TSA (using a spread plate technique) and incubate. 2. After incubation, add 3-4 drops of hydrogen peroxide to the surface of the colonies
growth.
Positive result is indicated by the presence catalase which causes bubbling or foaming of oxygen on the colonies surface
Negative result is indicated by absence of catalase- no bubbling occurs
hydrogen peroxide
is an end product of respiration in many bacteria. it is toxic substance and would eventually kill the organism if it were allowed to accumulate

superoxide dismutase
SOD is produced by some microorganisms to degrade toxic superoxides

What does a typical carbohydrate fermentation medium contain?
nutrient broth for support of all organism growth, specific carbohydrates (peptones) that determine their fermenting capabilities, and a pH indicator (phenol red)
What is the purpose of the phenol red and the Durham tube?
phenol red- to indicate slight amounts of acid produced by fermentation; it is red at neutral pH of 7, changes to yellow at slightly acidic at pH of 6.8
Durham tube- to trap gas that may be produced during fermentation; inverted tube in culture broth to indicate fermentation gas end products
What gas can be produced as a product of carbohydrate fermentation?
CO2
How do you know a Carbohydrate Fermentation test is positive or negative?
positive is indicated by acid and gas production- phenol red turns yellow and a gas bubble is trapped in the durham tube
Negative is indicated by no acid or gas production- phenol red stays red and no gas bubbles in durham tube
alkaline end products only- phenol red turns magenta
**if indicator stays red than= negative

What does catalase do?
rapidly degrades hydrogen peroxide to water and O2 gas
What is the chemical reaction involved in this test?
H2O2 (hydrogen peroxide)---catalase-----> 2 H2O (water) + O2 (free oxygen)
What reagent do you add to see if the test is positive or negative?
3% hydrogen peroxide
IMViC test definition
The IMVic test series is used to differentiate between the principal groups of Enterobacteriaceae (i.e. E.
coli, E. aerogenes, K. pneumoniae, etc) via based on their biochemical properties and enzymatic reactions in the presence of specific substrates
enterobacteriaceae
enteric bacteria; found in intestinal tract of mammals; short in size, gram neg, non-spore forming, bacilli (i.e pathogens- salmonella and shigella, occasional pathogens- proteus and klebsiells, and normal intestinal flora- escherichia and enterobacter)
Methyl-Red indicator
used in methyl red test. At pH range of 4 it turns red which indicates positive result
At pH of 6 it still shows presence of acid, but with lower H+ concentration, it turns yellow which indicates negative result

SIM agar deep

Kovac's reagent
Used in indole test: detects presence of indole; produces cherry red reagent layer if indole-positive, meaning tryptophan was hydrolyzed
MR-VP broth

baritts reagents
used in VP test- Barritt's reagents A and B; detects neutral end products like acetylmethylcarbinol
simmons citrate agar
selective agar

What does IMViC stand for?
Indole, Methyl-red (MR), Voges-proskauer (VP), Citrate utilization
How do you perform indole test?
following inoculation and incubation at 37 deg:
1. add 10 drops Kovac's to all deep tube cultures and agitate
2. examine color of reagent
Red color is a positive result.
how do you perform methyl red test?
following inoculation and incubation at 37 deg:
1. transfer 1/3 each culture to empty test tube
2. add 5 drops methyl red to each culture
3. examine color of all cultures
turns red color in acidic conditions (pH 4.4) and yellow at neutral or alkaline condition (pH 6.2)
how do you perform voges-proskauer test?
1. add 10 drops Barritt's reagent A to all aliquots from methyl red test and shake cultures
immediately add 10 drops of B and reshake every 3 to 4 min
2. examine color after 15 min
Red is positive for acetoin and yellow is negative.
how do you perform citrate utilization test?
following inoculation and incubation at 37 deg:
1. examine all agar slant cultures for presence or absence of growth
What is the purpose for indole test?
Indole- for differentiating Escherichia from enterobacter and klebsiella. Determines ability of microorganisms to degrade amino acid tryptophan using tryptophanase to produce indole. Serves as a biochemical marker.
purpose of methyl red test
to differentiate between all glucose fermenting enteric organism, particularly E.coli and E. aerogens, determines the ability of microorganisms to oxidize glucose into acidic
end products based on the enzymatic pathway used by the bacteria.
purpose of VP test
differentiate Enterobacter and Kleibsella from Escherichia, determines the ability of microorganisms to oxidize glucose into
non-acidic or neutral end products (acetoin or acetylmethylcarbinol) based on the enzymatic pathway used in the bacteria.
purpose of citrate
determines the ability of microorganisms to use citrate as a sole carbon source for energy. Citrate permease facilitates transport of citrate into the cell. The basic result is the alkalization of the culture medium.
Differentiate between a positive test and a negative test within the IMViC series
a) Indole-Red on deep surface- positive
yellow on deep surface- negative
b) methyl red test, Red broth-positive
yellow or orange broth- negative
c) VP test, Rose colored broth-positive
absence of rose color broth-negative
d)Citrate test, growth and/or blue coloration- positive
no growth and medium remains green-negative
What are the reagents you use to determine each test's result, positive or negative?
reagents used in-
Indole-Kovac's reagent
methyl red- methyl red indicator
VP- barritt's reagent
citrate utilization test-none
What family of bacteria does this test identify? (IMViC)
Enterobacteriaceae
What are the pathogens, the occasional pathogens, and normal intestinal flora included in this family?
Pathogens- members of the genera Salmonella and Shigella
Occasional Pathogen- members of genera Proteus and Klebsiella
Normal intestinal Flora- members of genera Escherichia and Enterobacter, they are saprophytic inhabitants of intestinal tract
What are the expected results of each bacterium and each test in the IMViC series?
1.Indole Production and methyl red test,Enterobacter aerogenes-negative, Escherichia coli-positive, Klebsiella pneumoniae-negative
2. VP and citrate, Enterobacter aerogenes- positive, Escherichia coli-negative, Klebsiella pneumoniae- positive
Define and diagram: antibody and antigen.
Antibody is a serum protein called an immunoglobulin (Ig) that reacts with a specific antigen, and are produced during an infection
Antigen- a substance, usually a large protein or polysaccharide, that when introduced into the body causes the immune response

Antigens
can be found on the surface of virus and cells
reacts with abx molecules and receptors on the lymphocytes

Epitope
actual portion or fragments of an antigen that react with receptors on B-lymphocytes
actual portions, and T-lymphocytes
